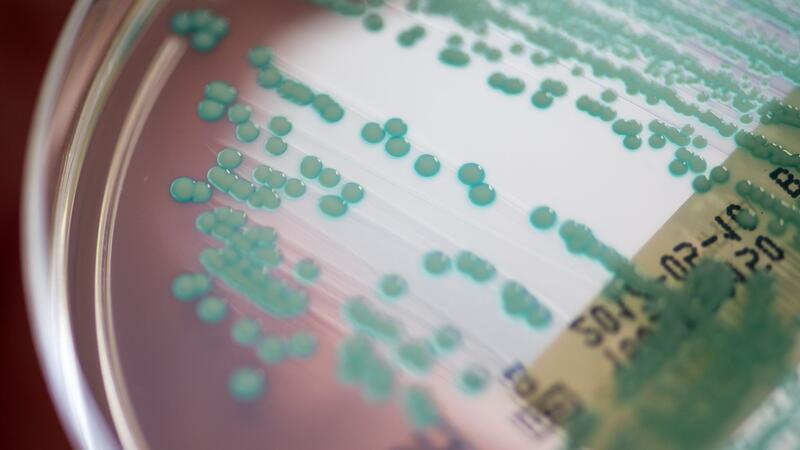

Datenanalyse: Antibiotika-Krise droht schlimmer zu werden
Jede Anwendung kann zur Vermehrung resistenter Bakterien führen, da diese dann einen Überlebensvorteil haben. (Archivbild) Foto: -/National Institute of Allergy and Infectious Diseases (NIAID)/dpa
Dass Antibiotika nicht mehr wirken, wird für die Menschheit zunehmend zum Problem. Forscher legen eine Prognose zur künftigen Entwicklung vor. Ihr Fazit: Es sind dringend neue Strategien nötig.
Seattle. Bis zum Jahr 2050 könnten weltweit mehr als 39 Millionen Menschen an Infektionen mit antibiotikaresistenten Keimen sterben, bei weiteren 169 Millionen Todesfällen könnten solche Erreger zumindest eine Rolle spielen. Zu diesem Ergebnis kommt eine umfassende Studie zu antimikrobiellen Wirkstoffen.
Eine entscheidende Ursache für die Zunahme von Resistenzen ist der übermäßige und unsachgemäße Einsatz von Antibiotika in der Human- und Veterinärmedizin. Jede Anwendung kann zur Vermehrung resistenter Bakterien führen, da diese dann einen Überlebensvorteil haben.
Die künftige Entwicklung abschätzen zu können, sei entscheidend für lebensrettende gegensteuernde Maßnahmen, sagte Mohsen Naghavi von der University of Washington, einer der Erstautoren der Studie.
Riesige Datenanalyse
Das Forschungsteam um Christopher Murray von der University of Washington in Seattle nutzte 520 Millionen Datensätze, um die Entwicklung der Antibiotikaresistenzen im Zeitraum von 1990 bis 2021 in einem Computermodell darzustellen. Auf dieser Basis entstand dann eine Prognose für die kommenden Jahre, die im Fachmagazin „The Lancet“ vorgestellt wird.
Das Modell der Forscher zeigte auch eine mögliche positive Entwicklung: Durch eine bessere Behandlung schwerer Infektionen und einen verbesserten Zugang zu Antibiotika könnten 92 Millionen Todesfälle zwischen 2025 und 2050 vermieden werden.
Wechselwirkung mit anderen Ursachen
Wie groß das Problem mit Resistenzen ist, lässt sich nicht so einfach ermitteln: Wenn beispielsweise bei der Behandlung einer Krebserkrankung Komplikationen durch multiresistente Keime auftreten, wird die Todesursache eines Patienten dennoch in der Regel dem Krebs zugeschrieben. Die Studienautoren nutzten Krankenhaus-Entlassungsdaten, Daten zu Todesursachen, Resistenzprofile einzelner Arzneimittel, Umfragen zum Antibiotikagebrauch und zahlreiche andere Quellen, um das Ausmaß der Resistenzen zu erfassen und das weltweite Modell zu entwickeln.
Von 1990 bis 2021 sind demnach jedes Jahr weltweit mehr als eine Million Menschen aufgrund antimikrobieller Resistenzen gestorben. Die Gesamtzahl stieg leicht, von 1,06 Millionen im Jahr 1990 auf 1,14 Millionen im Jahr 2021. Berücksichtigt man das Bevölkerungswachstum, sank die Todesrate pro 100.000 Menschen von 19,8 (1990) auf 14,5 (2021).
Vor allem Ältere betroffen
Allerdings ist die Entwicklung nach Altersgruppen sehr unterschiedlich: Während die Anzahl der resistenzbedingten Sterbefälle bei Kindern unter fünf Jahren um 50 Prozent gesenkt werden konnte, ist die Anzahl bei Menschen im Alter von 70 oder mehr Jahren um 80 Prozent gestiegen.
Mit Blick auf die Kleinkinder schreiben die Forschenden: „Ein Großteil dieser Reduzierung ist auf einen Rückgang medikamentenresistenter Streptococcus pneumoniae und von Krankheitserregern zurückzuführen, die üblicherweise durch fäkal-orale Übertragung verbreitet werden“. Dazu hätten vor allem Impfkampagnen und verbesserte hygienische Bedingungen beigetragen.
Den Anstieg der Fälle bei älteren Menschen führen die Forscher auf eine oft geringere Wirksamkeit oder Unverträglichkeit von Impfstoffen und Arzneimitteln bei Älteren sowie mehr Grunderkrankungen zurück.
Weil die Bevölkerungsgruppe der Über-64-Jährigen in den kommenden Jahren am stärksten wachsen wird, könnten sich auch die resistenzbedingten Todesfälle dem Modell zufolge bis 2050 insgesamt erhöhen: von 1,14 Millionen (2021) auf 1,91 Millionen (2050) pro Jahr. Die Zahl der Todesfälle, bei denen multiresistente Keime eine Rolle spielen, könnte der Modellrechnung zufolge von 4,71 Millionen auf 8,22 Millionen steigen.
Liste von Gegenmaßnahmen
„Um zu verhindern, dass dies zu einer tödlichen Realität wird, brauchen wir dringend neue Strategien, um das Risiko schwerer Infektionen zu senken, durch Impfstoffe, neue Medikamente, verbesserte Gesundheitsversorgung, besseren Zugang zu vorhandenen Antibiotika und Anleitungen zu deren effektivster Anwendung“, sagte Studienautor Stein Emil Vollset vom Norwegian Institute of Public Health.
Die Antibiotika-Krise betrifft nicht nur Staaten mit einem niedrigen oder mittleren Durchschnittseinkommen. So gehörten die USA und Kanada zu den fünf Weltregionen, in denen die resistenzbedingten Todesfälle zwischen 1990 und 2021 am stärksten gestiegen sind. Die weiteren Regionen sind das tropische Lateinamerika, Westafrika sowie Südasien und Südostasien.
Bis 2050 werden die höchsten Steigerungsraten in Südasien (darunter Indien), Lateinamerika und Karibik erwartet. „Diese Daten sollten Investitionen und gezielte Maßnahmen zur Bewältigung der wachsenden Herausforderung der antimikrobiellen Resistenzen in allen Regionen vorantreiben“, betonte Samuel Kariuki vom Kenya Medical Research Institute, der selbst nicht an der Studie beteiligt war.

Dass Antibiotika nicht mehr wirken, wird für die Menschheit zunehmend zum Problem. (Archivbild) Foto: Daniel Karmann/dpa

Eine Ursache für die Zunahme von Resistenzen ist der übermäßige und unsachgemäße Einsatz von Antibiotika in der Human- und Veterinärmedizin. (Archivbild) Foto: Monika Skolimowska/dpa
Die Zahl der Todesfälle, bei denen multiresistente Keime eine Rolle spielen, könnte von 4,71 Millionen auf 8,22 Millionen steigen. (Archivbild) Foto: Armin Weigel/dpa